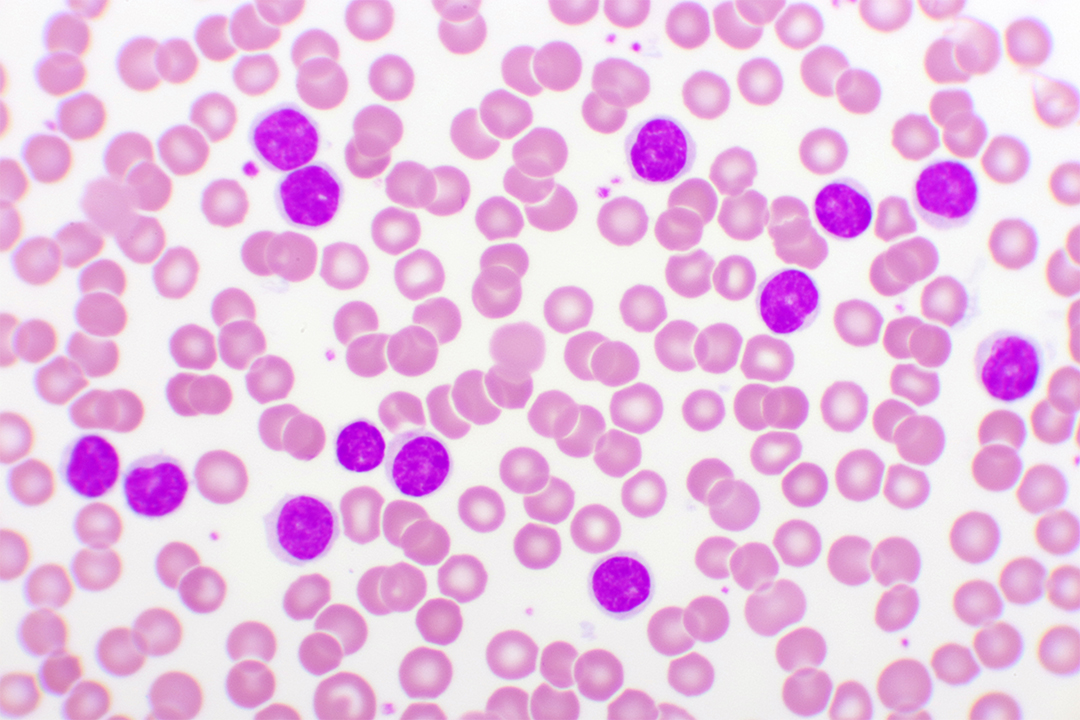
CLL Ansicht Mikroskop
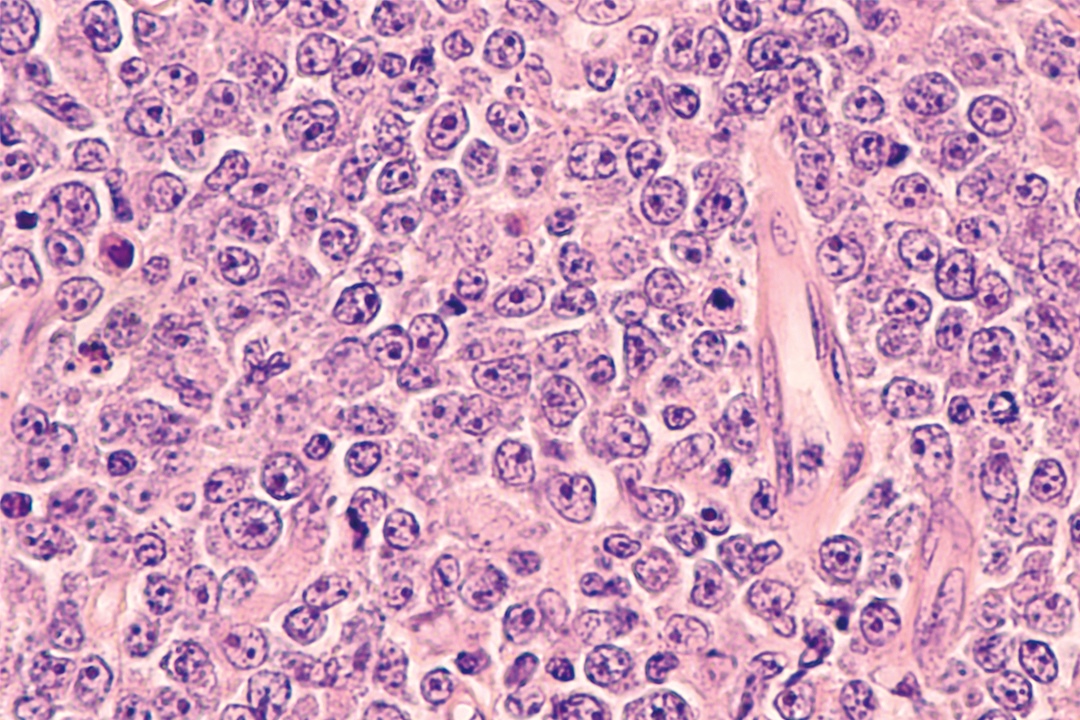
CLL Ansicht Mikroskop

Hämatoonkologie
Gemeinsam die Grenzen in der Krebstherapie verschieben!
Mit innovativen und effektiven Therapien möchten wir Menschen mit Blutkrebs ein besseres und längeres Leben ermöglichen. Dafür sind wir seit mehr als zehn Jahren in der onkologischen Forschung und Arzneimittelentwicklung aktiv.
Unsere empfohlenen Artikel & Events
Sehen Sie sich diese Artikel an, die für Sie von Interesse sein könnten.
Wähle einen Filter aus:
Angewendete Filter:
Thema
Entschuldigung, wir konnten keine Artikel finden, die mit deiner Auswahl übereinstimmen.
Filter zurücksetzen , um wieder alle verfügbaren Artikel zu sehen
AbbVies Zukunft in der Hämatoonkologie
Weitere Informationen:
Sie suchen nach detaillierten Informationen für Patient*innen?
Quellen
- Souers AJ et al. Nat Med 2013; 19:202–208.
- Anderson MA et al. Semin Hematol 2014; 51:219–227.